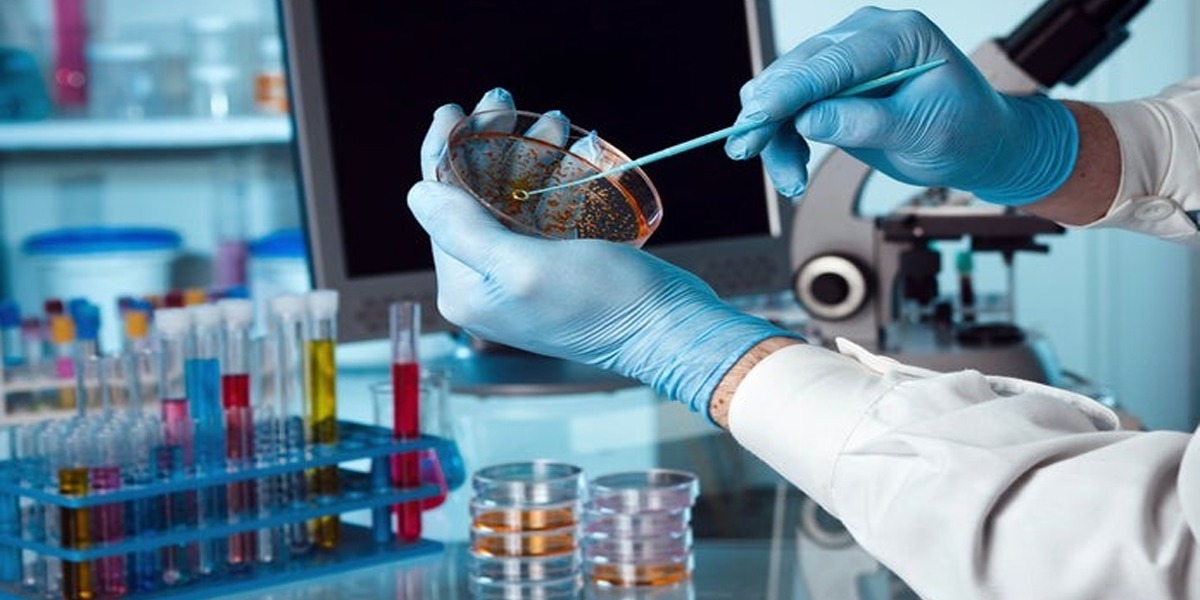

One of the most elegant and simple personalities of the showbiz industry, Syra Yousuf, never fails to impress her fans and netizens.
Syra became part of a controversy when the dating news of her ex-husband Shahroz Sabzwari circulated online with Sadaf Kanwal. However, Syra and Shahroz parted their ways. Syra Yousuf stayed silent in this whole scenario.
The actress’s fans and followers miss her on screens and they wanted to see her work more.
Recently, the elegant star spotted in the new advertisement. She looks absolutely stunning in a red royal dress and her styling was done by Mavi Kayani.